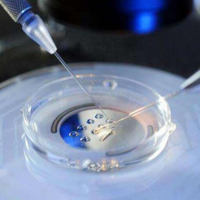

试管婴儿收费价目表分享,三代试管花费较高
一代试管婴儿总费用大约在2万至5万元之间,二代试管总费用约在5万至8万元左右,第三代试管婴儿的费用在8万至15万元之间。随着现代医学的不断发展,试管婴儿技术已经成为许多不孕不育夫妇实现生育梦想的救命稻草。这项技术已经相当成熟,很多人比较关心其费用,其实它的费用相对较高,且因不同代数和地区医院而有所差异,有需求的朋友可以参考以上价格。试管婴儿收费价目表分享试管婴儿是一种越来越受欢迎的生育方式,它为那

一代试管婴儿总费用大约在2万至5万元之间,二代试管总费用约在5万至8万元左右,第三代试管婴儿的费用在8万至15万元之间。随着现代医学的不断发展,试管婴儿技术已经成为许多不孕不育夫妇实现生育梦想的救命稻草。这项技术已经相当成熟,很多人比较关心其费用,其实它的费用相对较高,且因不同代数和地区医院而有所差异,有需求的朋友可以参考以上价格。试管婴儿收费价目表分享试管婴儿是一种越来越受欢迎的生育方式,它为那

三代试管移植费用比二代贵1500。一代试管婴儿移植的费用大概是1500,三代试管移植费用大概是3000元一次。第三代试管婴儿技术与第二代试管婴儿技术相比,通常包含更先进的辅助生殖技术和更高级的实验室方法,因此费用可能会更高。但以上费用差别仅供大家参考,费用的具体差异取决于医疗机构、地区、个体情况等因素,因此无法一概而论。三代试管婴儿技术相较于二代试管婴儿技术在费用方面可能会更高,大概贵5-8万元左

马来西亚第三代试管婴儿费用包括前期检查费用、促排卵药物费用、手术和操作费用。马来西亚试管费用包括妇科检查、男性精子检查、卵巢刺激治疗等,这些费用通常在数千至数万元之间,其次是药品费用,用于调节女性卵巢功能和促进卵泡生长的药物价格昂贵,一次治疗可能需要几千至数万元,最后是手术费用,包括取卵手术和胚胎移植手术,手术费用也是试管婴儿费用中不可或缺的一部分。马来西亚第三代试管婴儿详细费用马来西亚的第三代试

一般来说,在国内大城市的高端医院或专业生殖中心进行此类筛查的费用可能在2万至3万元人民币之间。然而,这一价格仅供参考,具体费用还应根据所选医院、医生以及个人具体情况来确定。在选择医院时,建议选择具有专业资质和良好口碑的医疗机构,以确保技术水平和治疗效果。同时,提前咨询医生,了解治疗流程、费用及注意事项,有助于合理规划治疗计划,降低费用支出。3代试管技术,即胚胎植入前遗传学诊断(PGD)或胚胎植入前

三代试管比一代、二代都贵。试管婴儿技术分为一、二、三代,其中一代技术最基础,价格也最低,大约每次3万元左右。二代技术比一代稍微先进一些,价格也相应提高,每次大约需要4万元左右。而三代技术是最先进的,价格也是最高的,每次大约需要5万元左右,具体的费用会因医院等级和当地的消费水平而有所差异,大家可以结合自己的实际情况来看。随着医疗技术的逐渐发展,我们国家的辅助生殖技术已经逐渐完善,目前已经有了一代试管

8-12万元左右。因为试管婴儿的费用包括术前检查、促排卵、取卵、受精、胚胎培养、移植等步骤,其中每个步骤的费用都有所不同,比如前期的身体检查费用可能需要花费2000-3000元左右,而促排药的费用可能会花费一万到一万五千元左右,三代试管移植和取卵的手术费用是在7-8万,具体的费用因医院和个人体质而有所不同,这个价格范围只能作为一个参考。第三代试管婴儿是在体外受精获得胚胎之后,对胚胎的遗传物质进行遗

近年来,随着生育需求的不断提高,越来越多的夫妇选择前往海外接受试管婴儿手术。泰国作为试管婴儿治疗的热门目的地,吸引了众多国内外夫妇。通常情况下,泰国三代试管婴儿手术的费用大约在10-20万人民币之间,主要包括了促排卵药物、术前检测、胚胎培养、移植等多个环节,本文为您整理了泰国试管婴儿的相关费用明细,以供您参考。泰国三代试管婴儿费用介绍第三代试管婴儿具有基因筛查功能,它可以防止有遗传病的婴幼儿出生,

去沈阳盛京医院做三代试管的话需要一次性缴费,大概费用在4-10万左右,如果首次试管没有成功,接下来要进行第二次的话,就会增加相应的费用。一般来说,试管婴儿第三孕产服务殖技术对于很多不孕不育的家庭来说,已经可以满足大多数人的需求,成功的概率也很高,但是试管的成功并不全部依赖技术,对于男女方的要求也是存在的,有任何一方出现问题,都有可能失败,这是需要注意的。我国对于试管婴儿的政策一直在推行,很多医院也在积

上海九院做一次三代试管其费用在5-10万元之间,主要包括试管检查费用、促排药品费、性染色体筛选费用、手术治疗费用等,此外,每个人三代试管的费用都会有差别,这主要与试管技术、个人身体状况、促排方案、额外的冷冻胚胎以及移植次数有关。有些人做试管婴儿一次就成功,那么费用就会少很多,有些人试管婴儿做了几次,试管费用就会比较多。三代试管婴儿技术,又称为胚胎基因组编辑技术(PGT),是一种辅助生殖技术,通过对
随着科技的发展,试管婴儿已经成为了现代不孕不育治疗的主流方式之一。试管婴儿成功率高,但是费用也是比较高昂的。而且,试管婴儿的费用是根据不同的用药方案而定的,因此,最终价格也是大有差别的。因此,在选择试管婴儿治疗方案时,需要根据自身的病情和经济情况进行选择,大家要是想要更加了解试管的费用,那么可以看一看20223试管收费价目表。20223试管费用明细试管婴儿的费用其实不管是在哪一年都没有太大的变动,

三代试管又叫做PGD和PGS,三代试管相较于第一代和第二代试管是最新的试管技术,有很多试管人群关心三代试管的条件及费用问题,今天我们就来对相关问题进行解答。PGD适用范围1.单基因病种:具有生育单基因遗传病子代高风险的夫妇,且家族中的致病基因突变诊断明确或致病基因联锁标记明确;2.夫妇任一方或双方携带染色体结构异常,包括罗氏易位、相互易位、复杂易位、致病性微缺失或微重复等;3.性染色体数目异常:4

通过做试管实现生育就不得不提试管一个周期所需要的费用,毕竟试管技术是用于辅助生育的技术,在应用和治疗上所需要的时间和精力都会比较多,自然的完成试管治疗后费用比较高,对部分家庭来说是有一定经济压力的。那么为什么做第三代试管价格会比前面两代要贵呢?三代试管的介绍试管婴儿技术的发展经历了三个代数,每个代数的突破和进步都给受孕希望渺茫的夫妇带来了希望和信心:1.第一代试管婴儿第一代试管婴儿技术是年代最远的






试管婴儿药物费用多少?一般在国内做一次试管婴儿费用大概在5~10万这个区间,药物费用要根据性质来看,进口药物会贵一些,国产的会便宜一些。

冷冻卵子费用多少钱,冷冻卵泡需要什么条件?目前国内冷冻卵子每次费用大概在1.5-2万元左右,但针对的主要是已婚人群,或者是需要进行化疗或放疗的女性。

试管婴儿年龄限制是多少岁?女人做试管婴儿最佳年龄是什么时候?女性做试管婴儿年龄最好是在35岁以前,年龄越大,试管成功率可能就越低,35岁以后就算是高龄了。

试管婴儿风险大吗对身体危害大吗?试管婴儿可能会对身体造成一些伤害,但在可接受范围内,主要是对女性的身体伤害,因为促排有副作用,取卵、打针是有创伤的。

单身做试管婴儿可以吗?未婚试管婴儿允许吗?单身女性也是可以做试管婴儿的,可以选择使用精子者的精子,国外是可以的,详情可以在线咨询。